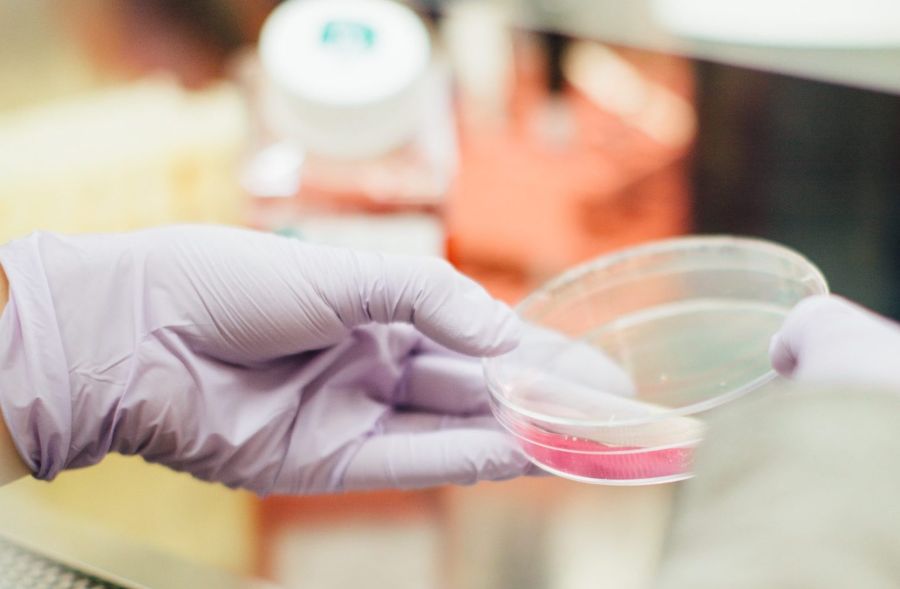

The increasing complexity of arbovirus serology: An in-depth systematic review on cross-reactivity
This publication is part of the project ‘Preparing for vector-borne virus outbreaks in a changing world: a One Health Approach’ (NWA.1160.1S.210) which is (partly) financed by the Dutch Research Council (NWO).

Authors: Louella M. R. Kasbergen , David F. Nieuwenhuijse, Erwin de Bruin, Reina S. Sikkema, Marion P. G. Koopmans
Abstract
Diagnosis of arbovirus infection or exposure by antibody testing is becoming increasingly difficult due to global expansion of arboviruses, which induce antibodies that may (cross-)react in serological assays. We provide a systematic review of the current knowledge and knowledge gaps in differential arbovirus serology. The search included Medline, Embase and Web of Science databases and identified 911 publications which were reduced to 102 after exclusion of studies not providing data on possible cross-reactivity or studies that did not meet the inclusion criteria regarding confirmation of virus exposure of reference population sets. Using a scoring system to further assess quality of studies, we show that the majority of the selected papers (N = 102) provides insufficient detail to support conclusions on specificity of serological outcomes with regards to elucidating antibody cross-reactivity. Along with the lack of standardization of assays, metadata such as time of illness onset, vaccination, infection and travel history, age and specificity of serological methods were most frequently missing. Given the critical role of serology for diagnosis and surveillance of arbovirus infections, better standards for reporting, as well as the development of more (standardized) specific serological assays that allow discrimination between exposures to multiple different arboviruses, are a large global unmet need.
Source: PLOS Neglected Tropical Diseases
Date: September 22, 2023